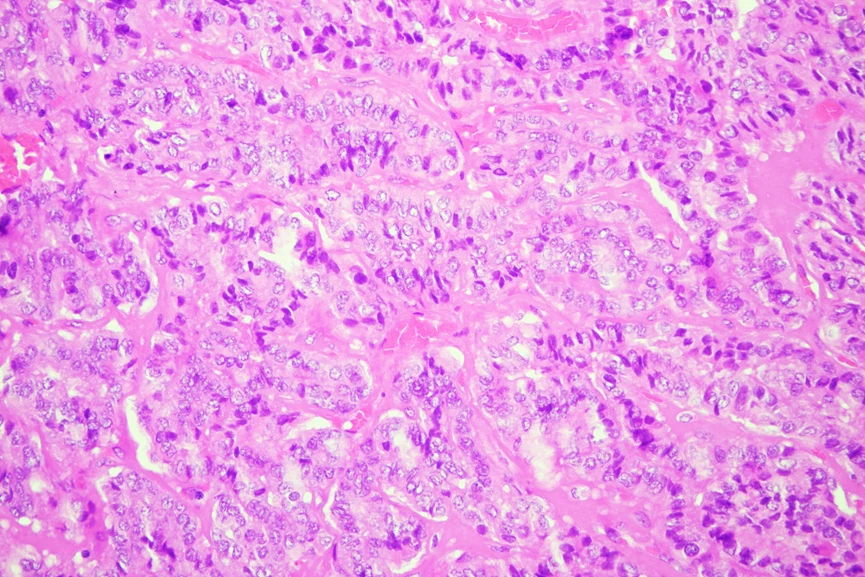

Mujer de 83 años con nódulo tiroideo izquierdo.
BAAF con diagnóstico de neoplasia folicular.
Para estudio transoperatorio se recibió hemitiroidectomia izquierda con un nódulo de 4.5 x 4.2 cm que ocupa el 95% del parénquima tiroideo.
Posteriormente se recibió producto de linfadenectomia cervical.

PREGUNTAS:
1. ¿Qué hallazgos en el transoperatorio, considera crucial para el diagnóstico?
a) Patrón papilar
b) Áreas de necrosis
c) Infiltración del tumor en tejido peritiroideo
d) Respuestas b y c correctas
e) Áreas típicas de carcinoma papilar
2. Como informaría el estudio transoperatorio?
a) Carcinoma de alto grado
b) Carcinoma papilar de tiroides
c) Carcinoma papilar de tiroides con patrón folicular
d) Carcinoma folicular
e) Carcinoma anaplásico
3. ¿Qué características histológicas se deben investigar intencionadamente dentro de esta lesión?
a) Componente sarcomatoso
b) Conteo mitósico
c) Áreas insulares
d) Núcleos en vidrio esmerilado, inclusiones citoplasmáticas
e) Todas las anteriores
4. Qué hallazgo molecular se encuentra comúnmente?
a) Mutación del gen KRAS
b) Mutación del Promotor TERT
c) Mutación BRAF V600E
d) Mutaciones TP53
e) Alteraciones de la vía PI3K.AKT-m TOR
5. Qué pronóstico tiene esta paciente?
a) Sobrevida a largo plazo
b) Tasa alta de recurrencia
c) Buena respuesta a tratamiento con yodo radioactivo
d) Progresión a un carcinoma anaplásico
e) Respuestas b y d correctas